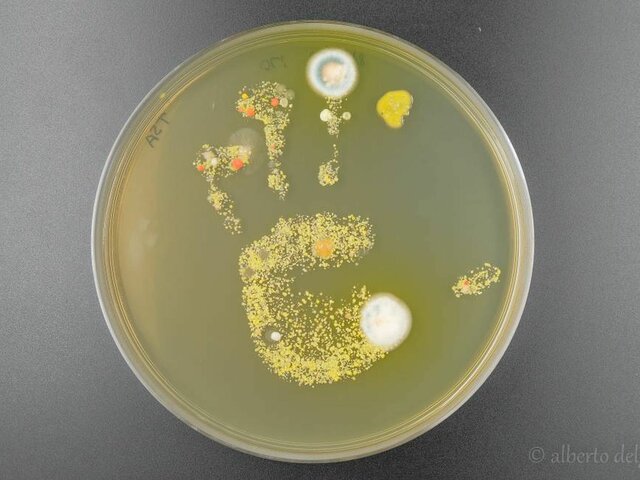
La teoría microbiana sin Pasteur y Koch

-
 La muerte negra de 1347 fue presagiada catorce años antes en china, por acontecimientos anormales que van desde fuertes sequias hasta abundantes lluvias y desde hundimentos de montañas hasta terremotos y huracanes y soplo de vientos apstados.
La muerte negra de 1347 fue presagiada catorce años antes en china, por acontecimientos anormales que van desde fuertes sequias hasta abundantes lluvias y desde hundimentos de montañas hasta terremotos y huracanes y soplo de vientos apstados. -
 Encuanto a la agricultura las primeras enfermedades infecciosas de plantas fueron " Samana y Mehru" fueron resgistradas en los fertiles valles de mesopotamia en el año 2000 a.C donde se cultivaba trigo y cebada.
Encuanto a la agricultura las primeras enfermedades infecciosas de plantas fueron " Samana y Mehru" fueron resgistradas en los fertiles valles de mesopotamia en el año 2000 a.C donde se cultivaba trigo y cebada.
pero mas adelnate se resgistraron enfermedades similares en la agricultura primitiva india, china y americana. -
 La teoría astral, cósmica o sideral es la que plantea en esencia que las estrellas y los planetas afectan el comportamiento de las personas y de las plantas y son los que le conceden un lugar privilegiado a la luna por sus efectos gravitacionales. Los horoscopos agricolas dueron muy populares en la agricultura primitiva e indigena y son un fiel testimonio de cómo la concepción astral permeó las actividades agrícolas.
La teoría astral, cósmica o sideral es la que plantea en esencia que las estrellas y los planetas afectan el comportamiento de las personas y de las plantas y son los que le conceden un lugar privilegiado a la luna por sus efectos gravitacionales. Los horoscopos agricolas dueron muy populares en la agricultura primitiva e indigena y son un fiel testimonio de cómo la concepción astral permeó las actividades agrícolas. -
 esta tuvo tres versiones
esta tuvo tres versiones
1 La ayurvédica de la india:en los escritos médicos
Charaka Samhita y Susruta Samhita, indica
el universo es la combinación de cinco elementos
(espacio, aire o viento, fuego, agua y tierra).
2 Las fuerzas opuestas yin-yangde china:El yin representa lo oscuro, lo frío, lo húmedo, lo negativo y lo femenino y el yang describe lo luminoso, lo cálido, lo seco,
lo positivo y lo masculino.
3 La de hipocrates: rompio con la concepción divina y sobrenatural de la enfermedad. -
 los miasmas eran exhalaciones pútridas y vapores o gases
los miasmas eran exhalaciones pútridas y vapores o gases
liberados por la materia orgánica vegetal o animal en descomposición.
En los albores de la teoría microbiana llegaron a ser considerados
como la combinación entre una entidad viviente y un veneno gaseoso. -
 Las investigaciones realizadas por Louis Pasteur y
Las investigaciones realizadas por Louis Pasteur y
Robert Koch, el primero sobre el gusano de seda y
la fermentación del vino y de la cerveza; y el segundo
sobre el ántrax y la tuberculosis. Dicha teoría rompió
con los viejos esquemas, se fundamentó en la
observación experimental y abrió la era del concepto
moderno de causalidad, apoyado en los atributos
de asociación, temporalidad y dirección -
Los investigadores dedicados al estudio de enfermedades de las plantas quienes aportaron la primera y auténtica prueba experimental, al menos 150 años antes de que lo hicieran Pasteur y Koch.
Los investigadores dedicados al estudio de enfermedades de las plantas quienes aportaron la primera y auténtica prueba experimental, al menos 150 años antes de que lo hicieran Pasteur y Koch.
Carter y Barnes lograron demostrar que un hongo era la causa necesaria y suficiente para que se desarrollara la enfermedad. -
 -Joseph Pitton de Tournefort clasificó las enfermedades de las plantas en externas e internas.
-Joseph Pitton de Tournefort clasificó las enfermedades de las plantas en externas e internas.
-John Baptiste Zallinger consideró cinco categorías de enfermedades de las plantas: flemasias o enfermedades inflamatorias, parálisis o debilidad, descarga o drenaje, caquexia o mala constitución y defectos o malformaciones de diferentes órganos.
-Cuando se dio el descubrimiento de microorganismos patógenos, la taxonomía ontogénica y etiológica surgieron las expresiones bacteriosis, micosis y virosis. -
 De acuerdo con Charles Bouchard, miembro de la Academia e Medicina de París y autor del texto "Los microbios patógenos" de 1892, las "enfermedades infecciosas" pueden ser específicas,
De acuerdo con Charles Bouchard, miembro de la Academia e Medicina de París y autor del texto "Los microbios patógenos" de 1892, las "enfermedades infecciosas" pueden ser específicas,
no específicas o parasíticas. Las específicas están asociadas con bacterias, hongos o animales como en el caso de la malaria; las no específicas se caracterizan por septicemias e inflamaciones y las
parasíticas son causadas por ácaros o por gusanos intestinales. -
 El profesor de Historia natural austríaco John Baptiste Zallinger, en una clara transposición del enfoque sintomatológico en Medicina, consideró cinco categorías de enfermedades de las plantas: flemasias o enfermedades inflamatorias, parálisis o debilidad,
El profesor de Historia natural austríaco John Baptiste Zallinger, en una clara transposición del enfoque sintomatológico en Medicina, consideró cinco categorías de enfermedades de las plantas: flemasias o enfermedades inflamatorias, parálisis o debilidad,
descarga o drenaje, caquexia o mala constitución y defectos o malformaciones de diferentes órganos.
A list shows items. A timeline shows sequence.
Use Timetoast to make dates, milestones, and turning points easier to understand in a clear visual format. Timetoast is a timeline maker for work, school, research, and stories.